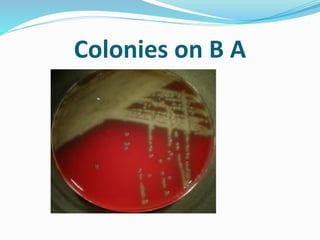
Colonies on B A
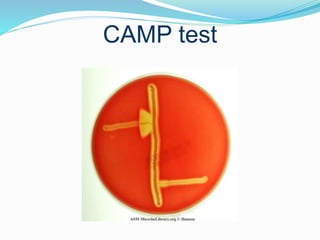
CAMP test

This document provides an overview of Streptococcus pneumoniae (pneumococcus). It is a gram-positive lance-shaped diplococcus that is a normal inhabitant of the upper respiratory tract. It causes pneumonia and other respiratory infections. Key characteristics include being bile soluble, optochin sensitive, and having a polysaccharide capsule that allows for serotyping. It is treated with penicillin but antibiotics resistance is a concern. Vaccines can help prevent pneumococcal disease.